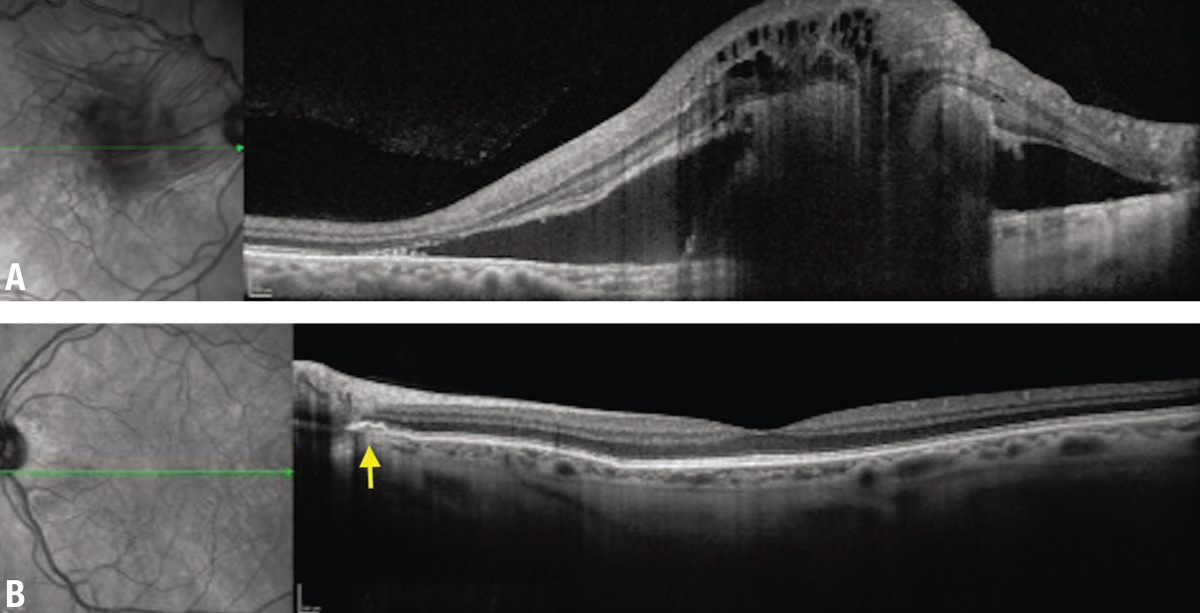

![]() |
|
Bios
Dr. Shahlaee is a vitreo- retinal fellow with Mid Atlantic Retina/Wills Eye Hospital, Philadelphia. Dr. Hsu is with Mid Atlantic Retina/Retina Service, Wills Eye Hospital. DISCLOSURES: Drs. Shahlaee and Hsu have no relevant financial relationships to disclose. |
A 59-year-old Caucasian male with a history of hypertension was referred for several months of painless vision loss in the right eye. He reported having central vision loss with worsening of symptoms over the preceding month. Peripheral vision was normal in both eyes. The patient had no known refractive error or notable ocular or surgical history.
Examination and imaging
On presentation, visual acuity was hand motion in the right eye and 20/25 in the left. Intraocular pressures were normal, extraocular movements were full and the pupillary exam was intact. The anterior segment examination was unremarkable.
Fundoscopic examination of the affected eye demonstrated a large serous detachment with a subretinal white lesion in the central macula and a sliver of subretinal hemorrhage (Figure 1). The fellow eye had circumpapillary pigmentary changes. On intravenous fluorescein angiography, the affected eye displayed a large central focus of leakage consistent with choroidal neovascularization (Figure 2).
![]() |
| Figure 1. Color fundus imaging demonstrates (A) a large serous detachment with a subretinal white lesion and overlying striations in the central macula, along with a sliver of subretinal hemorrhage in the right eye, and (B) circumpapillary pigmentary changes in the left eye. |
Angioid streaks
Angioid streaks represent breaks in Bruch’s membrane, appearing funduscopically as irregular, red or brown lines that radiate circumferentially from the optic nerve,1 although, as seen in this case, clinical findings may be subtle and better captured on multimodal imaging. Angioid streaks pose an imminent risk of choroidal neovascularization. Their interplay with systemic disorders requires an interdisciplinary approach to diagnosis and treatment. Various associated systemic conditions include pseudoxanthoma elasticum (PXE), Ehler-Danlos syndrome, Paget’s disease of bone, hematologic disorders (e.g., sickle cell disease) and diabetes mellitus.2
![]() |
| Figure 2. A) Intravenous fluorescein angiography shows a large central focus of hyperfluorescence. B) Concomitant leakage is consistent with choroidal neovascularization. |
The prevalence of PXE is estimated to be 1:25,000. It has been seen in at least half of the patients with angioid streaks.3,4 Despite the well-known association between PXE and angioid streaks, the wide array of clinical presentations for PXE—secondary to allelic heterogeneity—could make an early diagnosis challenging.5 While there’s no cure for PXE, the potential for underdiagnosis delays treatment and puts patients at serious risk for an otherwise preventable worsening of vision.6
The major criteria for the diagnosis of PXE include ophthalmologic, dermatologic and genetic findings, such as:
- peau d’orange—a French term meaning orange peel or orange skin—referring to the appearance of the fundus or presence of angioid streaks;
- the presence of yellow papules on the neck and/or flexural areas, demonstrating abnormal and calcified elastin fibers on skin biopsy; and
- a genetic analysis demonstrating a biallelic ABCC6 mutation.7
- The diagnosis is confirmed by the presence of two distinct categories of the three major criteria. Systemic associations include:
- premature gastrointestinal angina and/or bleeding;
- intermittent claudication of the arm and leg muscles; and
- stroke, renovascular hypertension, and cardiovascular complications, such as angina and myocardial infarction.
![]() |
| Figure 3. A) Optical coherence tomography of the right eye demonstrates marked subretinal and intraretinal fluid and a hyperreflective subretinal lesion. B) The left eye shows focal disruption in Bruch’s membrane adjacent to the disc (arrow). |
Depending on the patient’s symptoms, cardiovascular, gastrointestinal and vascular evaluations may also be warranted.7
Genetic testing
While various mutational culprits for PXE exist, the mutation most commonly associated with ocular involvement is in the adenosine triphosphate (ATP)-binding cassette subtype C number 6 (ABCC6) gene on chromosome 16p13.1.8 The ABCC6 gene encodes for a binding cassette that allows for the transcellular transport of ATP into the extracellular space, with subsequent conversion of ATP into adenosine monophosphate (AMP) and inorganic pyrophosphate.9
![]() |
| Figure 4. A) Fundus autofluorescence of the right eye shows a mixed stippled pattern. B) The left eye exhibits speckled radial linear hyper-autofluorescence patterns emanating from the disc in the left eye. |
A biallelic mutation in the ABCC6 gene disrupts this process and prevents the formation of inorganic pyrophosphate, which allows for ectopic mineralization. This induces breaks and calcification in the elastic fibers within connective tissues of the eyes, skin and peripheral arteries.10
In the eye, the elastic membranes of Bruch’s membrane become abnormally calcified, reducing the membranes’ structural integrity and resilience, with subsequent increased vulnerability to mechanical stressors. The weakened Bruch’s membrane is prone to breaks, otherwise known as angioid streaks.4 These breaks can result in endothelial dysfunction, which ultimately induces CNV via vascular endothelial growth factor activation.11
In our patient, genetic testing revealed a heterozygous mutation for ABCC6 c.4218G>C, p.(Gln1406His), a variant of uncertain significance. There have been reports of two individuals with autosomal recessive PXE with compound heterozygosity for a different nucleotide substitution at a similar protein position (ABCC6 c.4216C>A, p.(Gln1406Lys)).12,13
Nevertheless, our patient didn’t have the same substitution or evidence of compound heterozygosity because no additional pathologic variant was identified within the ABCC6 gene. While the genetic analysis covered 100 percent of the ABCC6 gene’s target region, the patient could have an as yet unidentified variant associated with PXE, a different variant not covered by the genetic analysis, or a variant that’s difficult to detect due to factors such as structural arrangements or the size of insertion-deletion mutations.
![]() |
| Figure 5. Inspection of the neck shows diffuse waxy, calcific papules resembling “plucked chicken skin.” |
Treatment
Vascular endothelial growth factor inhibitors are the primary treatment for CNV secondary to angioid streaks in the setting of PXE. They’ve been shown to improve vision, especially in patients with better baseline visual acuity.4 However, CNV recurrence or new CNV has been shown to occur frequently as early as six months after the last anti-VEGF treatment.14
Although photodynamic therapy and laser photocoagulation may also be used for CNV, these treatments have been associated with complications, including decreased vision, recurrence and progressive damage to the retina.4 Overall, existing and potential studies further emphasize the importance of early diagnosis of PXE to ensure preservation of visual acuity.
Racquet and contact sports carry an increased risk for ocular and head trauma, both of which have been reported to precipitate CNV in patients with angioid streaks. Patients with angioid streaks should be discouraged from participating in such activities. Individuals with PXE who participate in sports and physical recreation should wear appropriate protective eyewear, such as polycarbonate sports goggles and/or protective helmets with eye shields.8
Bottom line
The pathophysiology, clinical presentation and treatment of PXE have been well described in the peer-reviewed literature. However, the varying clinical and mutational features among different patients make a timely diagnosis more elusive. A diagnostic delay may have negative consequences, particularly with regards to visual outcomes. Here, we emphasize the importance of using multimodal imaging and a systematic approach to uncover the cause of the CNV. RS
REFERENCES
1. Gliem M, Finger RP, Fimmers R, Brinkmann CK, Holz FG, Issa PC. Treatment of choroidal neovascularization due to angioid streaks: A comprehensive review. Retina. 2013;33:1300-1314.
2. Georgalas I, Papaconstantinou D, Koutsandrea C, et al. Angioid streaks, clinical course, complications, and current therapeutic management. Ther Clin Risk Manag. 2009;5:81-89.
3. Chassaing N, Martin L, Calvas P, Le Bert M, Hovnanian A. Pseudoxanthoma elasticum: A clinical, pathophysiological and genetic update including 11 novel ABCC6 mutations. J Med Genet. 2005;42:881-892.
4. Connor Jr PJ, Juergens JL, Perry HO, Hollenhorst RW, Edwards JE. Pseudoxanthoma elasticum and angioid streaks: A review of 106 cases. Am J Med. 1961;30:537-543.
5. Chassaing N, Martin L, Mazereeuw J, Barrie L, Nizard S, Bonafe J-L, et al. Novel ABCC6 mutations in pseudoxanthoma elasticum. J Invest Dermatol. 2004;122:608-613.
6. Finger RP, Issa PC, Schmitz-Valckenberg S, Holz FG, Scholl HN. Long-term effectiveness of intravitreal bevacizumab for choroidal neovascularization secondary to angioid streaks in pseudoxanthoma elasticum. Retina. 2011;31:1268-1278.
7. Germain DP. Pseudoxanthoma elasticum. Orphanet J Rare Dis. 2017;12:85.
8. Uitto J, Jiang Q, Váradi A, Bercovitch LG, Terry SF. Pseudoxanthoma elasticum: Diagnostic features, classification and treatment options. Expert Opin Orphan Drugs. 2014;2:567-577.
9. Jansen RS, Duijst S, Mahakena S, Sommer D, Szeri F, Váradi A, et al. ABCC6–mediated ATP secretion by the liver is the main source of the mineralization inhibitor inorganic pyrophosphate in the systemic circulation—brief report. Arterioscler Thromb Vasc Biol. 2014;34:1985-1989.
10. Kranenburg G, de Jong PA, Bartstra JW, et al. Etidronate for prevention of ectopic mineralization in patients with pseudoxanthoma elasticum. J Am Coll Cardiol. 2018;71:1117-1126.
11. Yeo NJY, Chan EJJ, Cheung C. Choroidal neovascularization: Mechanisms of endothelial dysfunction. Front Pharmacol. 2019;10:1363.
12. Le Boulanger G, Labreze C, Croue A, et al. An unusual severe vascular case of pseudoxanthoma elasticum presenting as generalized arterial calcification of infancy. Am J Med Genet A. 2010;152:118-123.
13. Hosen MJ, Van Nieuwerburgh F, Steyaert W, Deforce D, Martin L, Leftheriotis G, et al. Efficiency of exome sequencing for the molecular diagnosis of pseudoxanthoma elasticum. J Invest Dermatol. 2015;135:992-998.
14. Sawa M, Gomi F, Tsujikawa M, Sakaguchi H, Tano Y. Long-term results of intravitreal bevacizumab injection for choroidal neovascularization secondary to angioid streaks. Am J Ophthalmol. 2009;148:584-590.